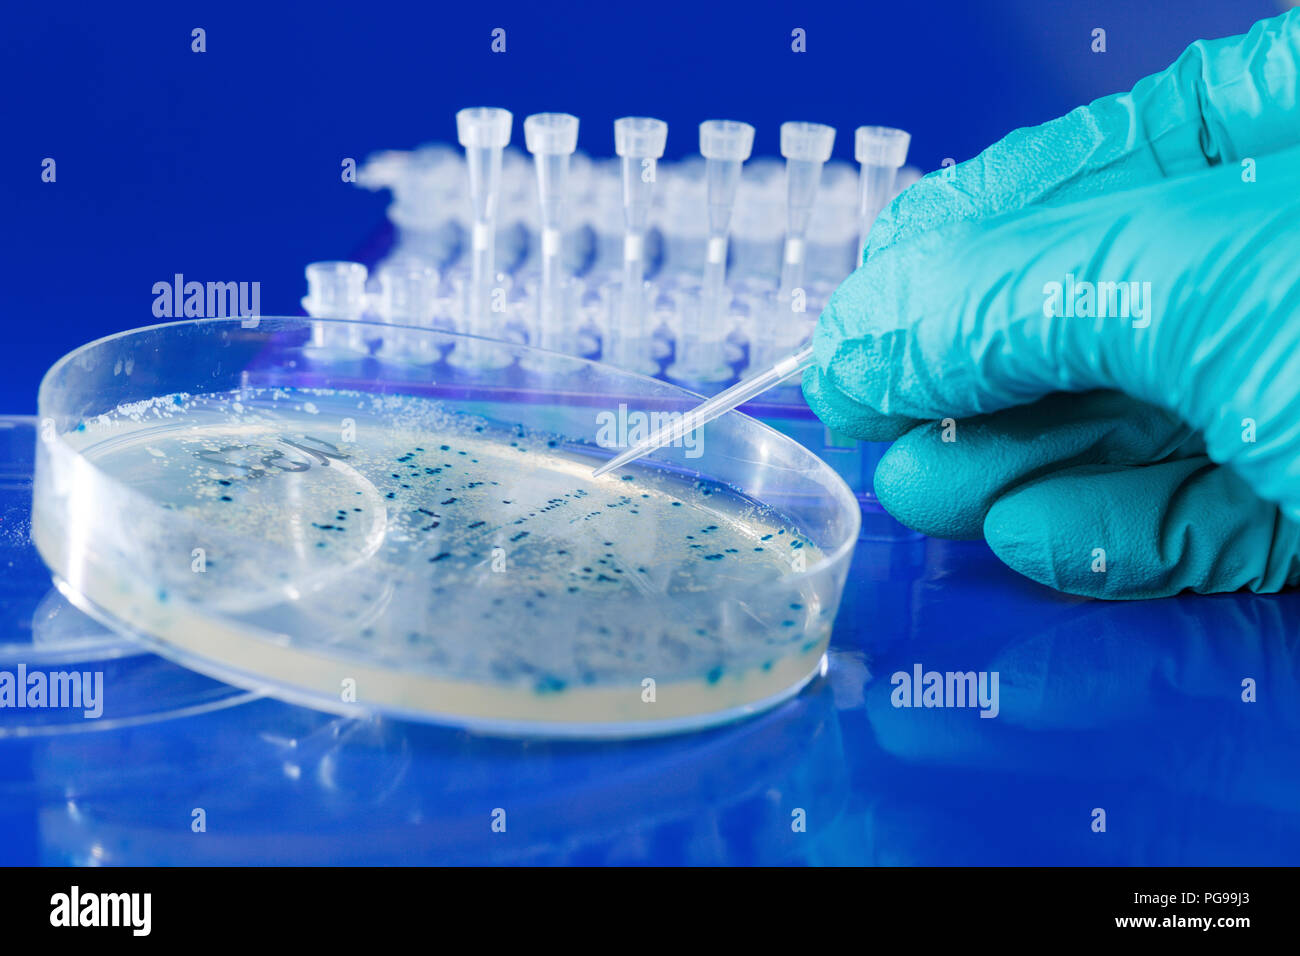

Под микроскопом: этапы культивирования микроорганизмов

.JPG)





































Раздел: Снимки-откровения